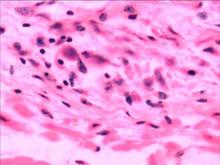
漢坦病毒

概述
漢坦病毒歸屬布尼亞病毒科,是一種有包膜分節段的負鏈RNA病毒,基因組包括L、M、S 3個片段,分別編碼L聚合酶蛋白、G1和G2糖蛋白、核蛋白。漢坦病毒包括引起腎綜合徵出血熱(HFRS)的漢灘病毒(Hantaan virus,HTNV)、漢城病毒(Seoul virus,SEOV)、普馬拉病毒(Puumala virus,PUUV)、多不拉伐病毒(Dobrava virus,DOBV),引起漢坦病毒肺綜合徵(HPS)的無名病毒(Sin Nombre virus,SNV)、紐約病毒(New York virus,NYV)、污黑小河溝病毒(Black Creek Canal virus,BCCNV)、牛軛湖病毒(Bayou virus,BAYV)、安第斯病毒(Andes virus,ANV)以及與人類疾病關係尚不清楚的一組病毒,如希望山病毒(Prospect Hill virus,PHV)、泰國病毒(Thailand virus,THAIV)、圖拉病毒(Tula virus,TULV)、索托帕拉雅病毒(Thottapalayam virus,TPMV)、哈巴羅夫斯基病毒(Khabarovsk virus,KBRV)、El Moro Canyon病毒(ELMCV)、Rio Segundo病毒(RIOSV)、島景病毒(Isla vista virus,ISLAV)、Muleshoe病毒(MULEV)、Bloodland lake病毒(BLLLV)、Rio Mamore病毒(RMV)、Topografov病毒(TOPV)等。近年來隨著新技術的套用和新型病毒的發現,漢坦病毒及其相關疾病的研究得以飛速發展。1998年3月5~7日,第四屆國際HFRS和漢坦病毒會議在美國亞特蘭大市召開,與會的世界各國學者和專家交流了這一領域的最新研究方法和研究成果。
分類及分布
漢坦病毒可兩種:引起漢坦病毒肺綜合徵(HPS),另一種引起漢坦病毒腎綜合徵出血熱(HFRS)。前者主要流行於美國,在阿根廷、巴西、巴拉圭、玻利維亞以及德國也發現了病例。中國雖未發現,但有發生的可能。主要臨床表現為,在4日左右的發熱、頭痛等前驅期症狀後,出現以非心源性肺水腫和高病死率(52.4%~78.0%)為特徵的急性呼吸衰竭,重症3~7日死亡,生存者則很快恢復,無後遺症。後者即中國常見的腎綜合徵出血熱,對其進行的分子生物學研究再一次證明其發病機制主要是病毒的直接致病作用,腎臟是早期原發性損傷器官,病毒是腎損傷的直接因素。
實驗診斷
 漢坦病毒
漢坦病毒漢坦病毒實驗診斷方面的研究,主要集中於重組抗原的套用和實驗診斷方法的快速、敏感和特異。F.Elgh等採用PUU病毒重組核蛋白作為抗原,與乳膠連線進行乳膠微粒凝集試驗,用於漢坦病毒病的快速血清學診斷,與採用PUU病毒重組核蛋白作為抗原的ELISA相比,特異性為90%,敏感性為94%。Jiro Arikawa等將桿狀病毒表達的HTN、SEO、PUU病毒核蛋白用於ELISA,至少套用2種重組抗原(HTN和PUU或SEO和PUU),可以用於漢坦病毒感染的血清學監測。桿狀病毒表達N端缺失的HTN或SEO病毒核蛋白作為免疫螢光試驗(IFA)的抗原,可以區分HTN與SEO病毒感染。重組核蛋白和N端缺失的核蛋白用於ELISA和IFA,提供了針對漢坦病毒感染的快速、敏感、安全的診斷方法。H.Kallio-Kokko等將桿狀病毒表達的PUU病毒核蛋白用於IgG和IgM檢測,將大腸桿菌表達的PUU病毒核蛋白用於IgM檢測,敏感性達100%,部分表達的核蛋白用於IgG檢測,敏感性較低(70%)。他們還報導了在PUU病毒感染的急性病例中,2/3的病例可以採用RT-PCR試驗,從病人的血或尿中檢出病毒RNA。T.Tomiyama等將高密度正性顆粒包被純化的漢坦病毒抗原,採用高密度顆粒凝集試驗(HDPA)對病毒感染進行快速血清學診斷,對HTN病毒感染的檢測有較高的敏感性和特異性,對PUU、SN病毒的感染也有低水平的交叉反應。HDPA與IFA比較,敏感性相近,但比IFA 更為簡便快速。W.Irwin等報告了現場調查中免疫印跡試驗在鼠類病毒抗體檢測中的套用。邱建明等採用5’端生物素標記漢灘病毒特異性寡核苷酸探針,結合磁性分離技術及改進的異硫氰酸胍-酚一步法兩種方法提取病毒RNA,進行反轉錄套式PCR,用於檢測臨床HFRS病人血清。在7d以內病人血清的陽性檢出率為100%,8~14d病人血清的陽性檢出率為57.14%,15d後病人血清仍能檢測到22.73%陽性。擴增產物經打點雜交檢測證實為特異性擴增,這為早期確診HFRS病人提供了特異、敏感、快速、直接的診斷方法。
基因分析
各國學者採用病毒與宿主的基因分析方法,研究漢坦病毒分離株之間或宿主動物之間親緣關係的遠近,以及病毒與宿主動物的共演化。
漢坦病毒基因分析
 漢坦病毒
漢坦病毒J.W.Song等從韓國絨鼠(Eothenomys regulus)分離了兩株PUU相關病毒,命名為Muju(MUJ)病毒。兩株病毒G2基因241bp片段序列存在1.2%差異,G2基因241bp片段和S基因208bp片段與PUU病毒相應片段序列的同源性分別為79.5%~83.4%和80.3%~81.2%。L.Yashina等從俄羅斯遠東鼠(Clethrionomys)、姬鼠(Apodemus)和HFRS病人分離的HTN病毒,M片段序列同源性86%~89%,從輕型HFRS病人分離的SEO病毒,M片段序列同源性97%。M.Drebot首次報告了加拿大草原田鼠攜帶PH樣病毒。加拿大不同省份SN病毒M、S片段序列存在25%的差異,並且加拿大西部SN病毒株與加拿大東部SN病毒株相比,毒株間基因序列更為接近。Yong-Kyu Chu等報告來源於印尼板齒鼠的病毒株可被SEO型特異引物擴增,M片段290bp序列分析表明與SEO病毒有7%的差異;來源於泰國板齒鼠的病毒株中,2株為SEO病毒,另1株可被HTN型特異引物擴增,M片段290bp序列分析表明與THAI 749毒株有1%的差異。J.W.Song等將來自波蘭的TUL病毒與俄羅斯中部和捷克斯洛伐克共和國的TUL病毒比較,核蛋白與G2糖蛋白胺基酸序列同源性大於96%,系統發生分析表明波蘭的TUL病毒與俄羅斯中部TUL病毒最為接近,但也存在差異。C.Sibold等的另一項研究——對核蛋白編碼基因進行系統發生分析表明,西斯洛伐克TUL病毒與捷克TUL病毒相近,東斯洛伐克TUL病毒與俄羅斯中部TUL病毒相近;而3’-NCR的系統發生分析表明,東斯洛伐克TUL病毒與西斯洛伐克和捷克的TUL病毒相近。作者認為,存在東斯洛伐克TUL病毒從中歐和俄羅斯TUL病毒重組的可能性。
宿主動物基因分析
多採用細胞色素B基因分析方法。W.C.Black IV等採用微衛星DNA分析確定鹿鼠之間的基因關係,並研究了鼠類窩內漢坦病毒傳播的方式。
病毒與宿主動物的共演化
漢坦病毒
漢坦病毒俄羅斯遠東地區南部的7種宿主動物中存在4種漢坦病毒(HTN、PUU、SEO、KBR)。L.Minskaya等的研究表明,從非主要宿主動物分離的病毒與標準株抗原性接近,但在基因分子特徵上與從主要宿主動物分離的病毒不同。A.Vaheri等的研究表明,西伯利亞旅鼠分離的TOP病毒與東方田鼠分離的KBR病毒S片段同源性核苷酸水平為82%,胺基酸水平為96%;與歐洲棕背分離的PUU病毒S片段同源性核苷酸水平為77%,胺基酸水平為87%。系統發生分析顯示3種病毒具有共同的起源,與相應宿主動物細胞色素B基因系統發生分析結果相一致,表明3種病毒進化過程中有在宿主動物之間進行的水平傳播。其中TOP病毒M、S片段3’-NCR最長,可能在3種漢坦病毒中起源最早。J.W.Song等報告韓國姬鼠來源的不同HTN病毒株,M基因324bp片段同源性95%~99%,姬鼠細胞色素B基因424bp和線粒體DNA D-環區序列差異性0%~3.1%,表明韓國不同地區姬鼠有相同的基因背景,HTN病毒具有相同的來源,在韓國沒有發現HTN病毒株與其宿主動物共同發生較大變異的現象。Heiske A.等進行的系統發生分析表明,歐洲西部PUU病毒與瑞典、芬蘭、俄羅斯的PUU病毒不同,同一分枝PUU病毒S片段開放讀碼框架基因差異性小於8%,不同分枝PUU病毒S片段開放讀碼框架基因差異大於14%。同一分枝PUU病毒核蛋白胺基酸序列差異0%~2%,不同分枝PUU病毒核蛋白胺基酸序列差異3%~5%。有資料表明,不同地區的歐洲棕背可以分為幾個亞類,這一研究支持了PUU病毒與其宿主動物共演化的觀點。L.Ivanov等對來源於俄羅斯遠東地區東方田鼠的KBR病毒進行研究,結果表明不同KRB病毒株間存在0.5%~4.0%的基因差異,基因差異與捕鼠地區的關係大於與捕鼠年份的關係,表明KBR病毒與東方田鼠之間存在長期的共演化過程。
疫苗與抗病毒研究
 漢坦病毒
漢坦病毒近年來HFRS疫苗的研製取得了較大的進展,有些類型的疫苗已經國家批准生產使用,有的已進入臨床觀察中,有的正在試驗室研製和檢測中。中國已經研製成功並試生產的3種單價滅活疫苗經大面積人群接種觀察,安全性較好,並具有較好的血清學和流行病學效果。近期(基礎免疫後1年)和中期(基礎免疫後2年)平均保護率,Ⅱ型地鼠苗分別為97.81%、88.73%;Ⅰ型上海沙鼠苗分別為94.08%、91.72%;Ⅰ型天元沙鼠苗均為100.00%;Ⅰ型鼠腦苗分別為88.45%、100.00%。滅活雙價沙鼠腎疫苗進行的Ⅱ期臨床試驗,總反應率為2.5%,3針後免疫螢光抗體陽轉率100.00%,中和抗體陽轉率87.6%(針對Ⅰ型病毒)和96.3%(針對Ⅱ型病毒),單一血清型陽轉率100.00%,兩種血清型同時陽轉率75.00%。韓國生產的漢坦病毒滅活鼠腦疫苗(Hantavax)的研究表明,基礎免疫1年後免疫螢光試驗和高密度顆粒凝集試驗檢測血清抗體陽性率分別為42.5%和45%,中和抗體陽性率13%。基礎免疫1年時加強免疫後,血清抗體陽性率92%,中和抗體陽性率升高至80%。此外,D.Koletzki等構建了攜帶漢坦病毒核蛋白基因的B肝病毒嵌合體,在使用和不使用佐劑的條件下免疫動物,都產生針對B肝病毒和漢坦病毒的特異抗體。K.Kamrud等對裸病毒DNA和甲病毒表達的漢坦病毒進行了評價。採用噬菌體呈現技術,C.de Carvalho Nicacio等、Tuomas Heiskanen等和梁米芳等分別研製了抗漢坦病毒的重組抗體,為未來HFRS的免疫治療開闢了前景。W.E.Severson等報告了病毒唑對漢坦病毒複製的影響。
分子生物學和細胞生物學
 實驗室診斷
實驗室診斷各國學者在多方面進行了漢坦病毒的分子生物學和細胞生物學研究。T.M.Welzel等和白雪帆等採用基因片段噬菌體表面呈現技術,研究了漢坦病毒單克隆抗體識別位點。E.Mackow等製備了針對桿狀病毒表達的SN病毒核蛋白的單克隆抗體,用於HPS相關病毒的血清學分型研究,並通過NY-1病毒核蛋白突變研究了單克隆抗體的識別位點。J.W.Hooper等用含有漢坦病毒反基因組的質粒DNA轉染Vero-E6細胞後,可以用免疫沉澱的方法檢出所表達的NP和G1、G2糖蛋白,但不能用生化和功能分析檢出聚合酶蛋白,也未檢出感染性病毒。B.Anheier等的研究表明,漢坦病毒G1、G2聚合物在高爾基體的定位由G1蛋白引導,G2蛋白穩定分子定位,G1蛋白胺基酸的變化可能改變G1結構,進而影響聚合物的形成。E.V.Ravkov等的研究表明,BCC病毒核蛋白與肌動朊纖維相互作用,可能在漢坦病毒的裝配和/或釋放過程中起重要作用。B.J.Meyer等採用Northern雜交、RNase保護試驗、RT-PCR、克隆測序等方法,對漢坦病毒在Vero-E6細胞內的持續感染進行了研究。
流行病學
智利1995年發現首例HPS病人,1995年10月至1997年7月發病僅8例,1997年10~12月發病20例,涉及全國11個地區,平均發病年齡29.7歲,病死率61%。病毒基因分析表明,發病主要由Andes病毒引起。作者認為,HPS病例的增加與當地漢坦病毒宿主動物數量的增加有關。俄羅斯1978~1996年共發生HFRS91 639例,分布於89個行政區中的61個,其中96.4%來自俄羅斯歐洲部分,3.6%來自亞洲部分,年平均死亡率分別為4.0/10萬和0.6/10萬。血清學和基因分型表明,俄羅斯至少存在6種血清型的漢坦病毒:HTN、PUU、SEO、TUL、KRB、TOP。比利時1995年10月至1996年12月發生HFRS 199例,季節分布表現為冬春季的小高峰和夏秋季的大高峰,病人主要為PUU血清型感染。加拿大截止1997年11月共發生HPS 21例,分布於3個西部省份,病死率33%,流行病學調查表明全國都有攜帶病毒的宿主動物分布,而HPS發病與接觸鼠類的機會有關。日本從17個海港中的16個和3個飛機場中的2個檢出宿主動物攜帶漢坦病毒,作者提出應建立監測體系並採取相應預防措施,檢查人群病毒感染率。
生態學
氣候、鼠類棲息地條件、鼠類繁殖強度、種群構成等因素的變化影響鼠密度,而宿主動物病毒感染率隨著時間和地點的不同不斷發生變化。不同的鼠密度、宿主動物病毒感染率和與人群接觸的機會,影響疾病的暴發或散發。T.S.Chiueh等對台灣進行的血清流行病學研究表明,當地雖然沒有確診的HFRS病人,在宿主動物中卻存在漢坦病毒的感染,在與鼠類接觸的職業人群和慢性腎衰及發熱病人中,血清抗體陽性率較高。C.Ahlm等報告瑞典北部野生駝鹿具有較低的漢坦病毒感染率。Yun-Tai Lee等發現,韓國蝙蝠、棕頭鴉雀攜帶PUU病毒。O.A.Alexeyev等的研究表明,在PUU抗體陽性歐洲棕背中,大部分(74%)不能檢出病毒RNA或抗原,也不具有感染性。此外,為表示漢坦病毒株對Vero-E6細胞適應能力與宿主動物種類的關係,L.Ivanov等用鼠肺標本漢坦病毒抗原滴度、病毒分離成功率、病毒分離天數等計算適應指數,黑線姬鼠為0.32,大林姬鼠為0.17,東方田鼠為0.10,棕背為0.06。
臨床
多項報告對HFRS和HPS的後遺症進行了調查,研究表明兩種疾病的恢復病人與健康人比較,分別存在腎臟或肺功能的異常。M.Howard等對患有HPS的孕婦進行了調查,結果表明患有HPS的孕婦預後與其他HPS患者相同,患有HPS孕婦的胎兒與其他患有成人呼吸窘迫綜合徵的孕婦的胎兒差異不大,研究中沒有發現SN病毒在人類垂直傳播的現象。
病理與免疫反應
 血液透析
血液透析HL Van Epps等研究了針對HTN病毒感染的人T淋巴細胞的反應,包括針對核蛋白或G1蛋白的和T細胞系,部分針對核蛋白的 T細胞系與無名病毒核蛋白有交叉反應,而針對核蛋白或G1蛋白的 T細胞系與無名病毒蛋白沒有交叉反應。這種引起不同漢坦病毒病(HFRS和HPS)的毒株,人T細胞系的交叉反應在病理研究和疫苗研製中具有重要意義。F.A.Ennis等進行的另一項研究,從HPS病人血中分離和 T細胞系,有些細胞系識別的區域在不同漢坦病毒株間相對保守,但有些T細胞系不能識別漢坦病毒單一的胺基酸改變,另一些T細胞系能識別關係較遠的分離株,如安第斯和普馬拉病毒的相應區域。C.Mansilla等對安第斯病毒致死病人屍檢結果表明,Andes-HPS和SNV-HPS引起的病理改變和病毒抗原分布相似,但Andes-HPS病例發現有充血性心肌炎和Ⅱ型肺單核細胞活性,並有較多的肝染色。M.Bharadwaj等從Andes-HPS病人氣管中檢出病毒RNA,認為安第斯病毒可能在人-人間傳播。還有報告研究了血組胺和緩激肽、類脂過氧化物、血管加壓素、溶酶體、紅細胞膜腺苷三磷酸酶等在HFRS病理改變中的作用。S.C.St Jeor等研究了SN病毒在鹿鼠體內的持續感染,感染後幾周至幾個月內,隨著抗體水平的增高,血清中病毒消失,其他組織中病毒減少。Karen L.Hutchinson等研究了BCC病毒在刺毛棉鼠體內的感染,感染後前幾周,定量PCR在除血液外的各組織中檢出病毒cRNA,以後病毒cRNA減少,感染5個月後只在腦內檢出;感染後1周血液中存在感染性病毒,2周時達高峰,3周時顯著減少;感染後5個月在腎上腺、肝、腎、睪丸仍可低水平檢出感染性病毒;感染後70d內尿中可分離到病毒;感染14d後可檢出BCC抗體。楊守敬等的研究表明,HFRS的休克和出血引起的局部缺血可以導致熱休克反應,在病人組織中表達72KD和73KD的熱休克蛋白,保護組織細胞免於損傷。他們的另一項研究,通過增生細胞核抗原以及細胞分裂中波形蛋白抗體的檢測表明,在HFRS組織損傷過程中,存在細胞的再生和DNA的修復,修復程度與損傷的嚴重程度有關。
HFRS是嚴重危害我國人民健康的病毒性疾病之一。自80年代初成功分離病毒以來,HFRS和漢坦病毒的研究取得了大量成果,尤其近年來滅活疫苗的研製成功,為有效預防本病創造了條件。但我們在病原學、實驗診斷、免疫病理和分子生物學等方面與國外研究尚有差距,仍存在許多有待解決的問題。隨著今後研究的深入,對本病認識的逐步加深,才能最終有效控制本病在我國的流行。
治療原則
早期抗病毒治療
HFRS的發病主要是病毒直接作用所致,病毒血症及外周血單核細胞內病毒存在的時間一般 為7~10日或長,早期抗病毒治療可阻斷病理損傷、減輕病情、降低病死率。套用干擾素、利巴韋林,有肯定療效。7病日以內均可套用,療程5~7日。
合理的綜合液體療法是最重要的治療措施
應強調預防性治療,不同病期有不同的液體療法原則。以平衡鹽液為主,根據化驗檢查結果,適當調整其成分及用量。應積極糾正低蛋白血症。
早期預防腎臟損傷
發熱期腎臟損傷程度較輕,由於多種因素,如血漿滲出、血液濃縮、血容量不足、合併DIC等而使腎損傷加重。故應針對上述因素,採取相應措施,是改善本病轉歸的重要策略。
少尿期尿毒症以及各種併發症
如高血容量、高血壓、心衰、肺水腫、腔道大出血、神經系統合併症及腎破裂是致死的五大因素,均發生於急性腎功能衰竭尿毒症期,血液透析是降低病死率的最重要的挽救生命的手段,應廣泛套用。
美國國家公園突發漢坦病毒
美國加利福尼亞州度假勝地優勝美地國家公園宿營區近日出現致命漢坦病毒感染病症,截至9月7日致死人數已經上升至3人。
據悉,第3名死者來自美國西維吉尼亞州,目前確認感染漢坦病毒的總人數已經達到8人,並且有可能繼續上升。
此前的2名死者分別來自美國加利福尼亞州和賓夕法尼亞州。其他感染者均來自加利福尼亞州,公園工作人員稱他們的病情已經有所緩解。
據悉,美國衛生官員已向39個國家發出警告,稱今年夏天曾在優勝美地國家公園宿營的該國公民可能感染致命的漢坦病毒。
專家稱,大約有1萬人因6月到8月期間去過優勝美地國家公園而存在感染漢坦病毒肺綜合徵的風險,其中約2500人來自美國以外的國家。目前尚無治癒該疾病的方法,但通過血液檢查及早發現可以極大地提高生存機率。

